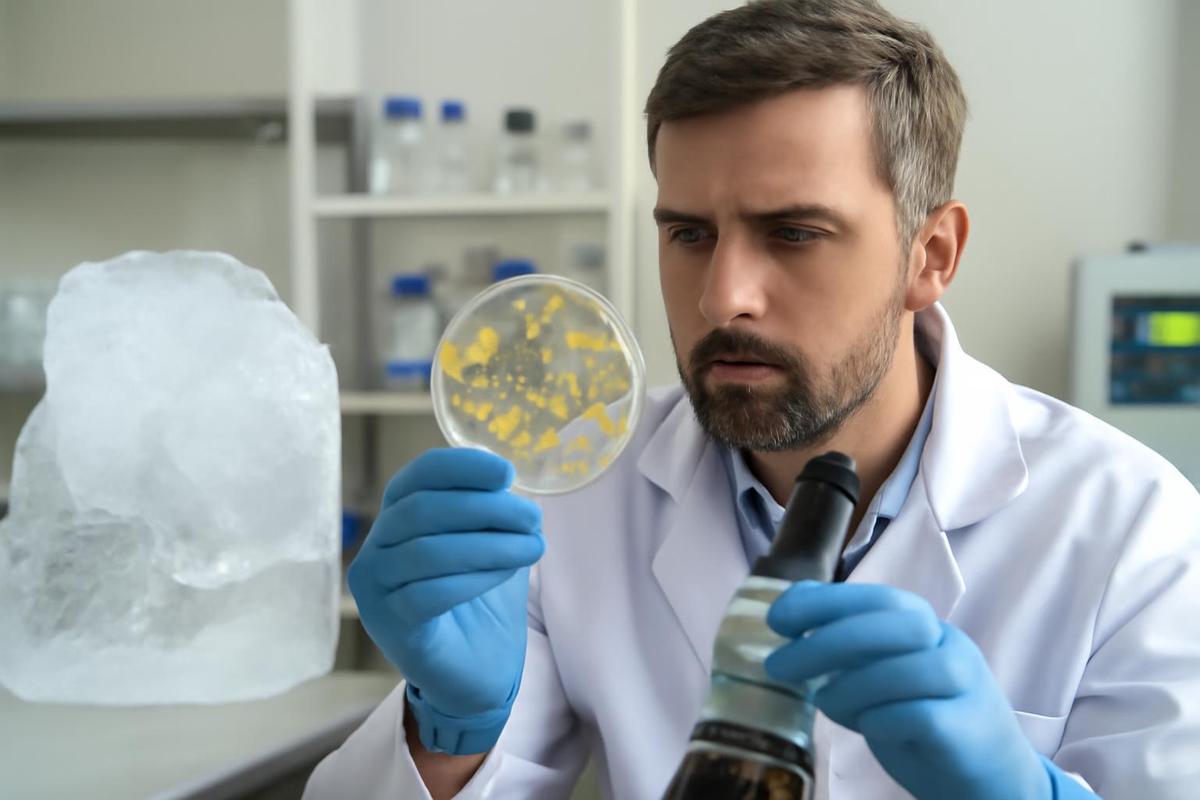

Bacterias de una cueva de hielo de 5,000 años desafían a los antibióticos modernos
Científicos hallaron en una cueva de hielo de Rumania una bacteria que, a pesar de su antigüedad, muestra resistencia a antibióticos modernos y podría ofrecer nuevas oportunidades en biotecnología.
22/02/2026 | 19:50Redacción Cadena 3
Las bacterias son organismos extraordinariamente adaptables, capaces de sobrevivir en los ambientes más extremos del planeta, desde aguas termales a congeladores. Recientemente, investigadores de Rumania descubrieron una bacteria en una capa de hielo de 5,000 años de antigüedad, dentro de la Cueva Scarisoara. Este hallazgo, publicado en la revista Frontiers in Microbiology, reveló que la bacteria posee una sorprendente resistencia a múltiples antibióticos modernos.
El equipo de científicos analizó la cepa bacteriana denominada Psychrobacter SC65A.3, que no solo ha sobrevivido a las inclemencias del tiempo, sino que también presenta más de 100 genes relacionados con la resistencia a antibióticos. Según la doctora Cristina Purcarea, científica del Instituto de Biología de Bucarest, "esta bacteria puede inhibir el crecimiento de varias superbacterias resistentes a antibióticos y muestra actividades enzimáticas significativas con un gran potencial biotecnológico".
La cepa Psychrobacter SC65A.3 pertenece a un grupo de bacterias adaptadas al frío. Aunque algunas de estas bacterias pueden causar infecciones en humanos y animales, se consideran prometedoras para aplicaciones biotecnológicas. La investigación sugiere que el estudio de microorganismos como Psychrobacter SC65A.3, extraídos de depósitos de hielo milenarios, puede arrojar luz sobre cómo la resistencia a los antibióticos se desarrolló de manera natural en el medio ambiente, mucho antes de la introducción de los antibióticos modernos.
Para recuperar esta bacteria, los investigadores perforaron un núcleo de hielo de 25 metros en la sección conocida como el Gran Salón de la cueva, capturando un registro congelado que abarca 13,000 años. Las muestras de hielo fueron selladas en bolsas estériles y transportadas en condiciones de congelación al laboratorio, donde se aislaron las cepas bacterianas y se secuenciaron sus genomas.
Los científicos probaron la cepa SC65A.3 contra 28 antibióticos de 10 clases diferentes, los cuales son comúnmente recetados para tratar infecciones bacterianas graves. Entre los antibióticos a los que mostró resistencia se encontraban rifampicina, vancomicina y ciprofloxacina, utilizados para tratar enfermedades como la tuberculosis y las infecciones del tracto urinario.
Esta cepa es la primera de su tipo en mostrar resistencia a antibióticos como trimetoprim, clindamicina y metronidazol, que se utilizan comúnmente para tratar infecciones del tracto urinario y otras afecciones. La resistencia observada sugiere que las bacterias adaptadas a ambientes fríos podrían actuar como reservorios de genes de resistencia.
El descubrimiento de esta bacteria plantea tanto riesgos como oportunidades. La doctora Purcarea advirtió que "si el hielo que se derrite libera estos microorganismos, esos genes podrían propagarse a las bacterias modernas, complicando aún más el problema global de la resistencia a los antibióticos". Sin embargo, también enfatizó que estas bacterias producen enzimas y compuestos antimicrobianos únicos que podrían inspirar el desarrollo de nuevos antibióticos y otras innovaciones biotecnológicas.
El análisis genético de Psychrobacter SC65A.3 reveló casi 600 genes con funciones desconocidas, lo que sugiere un recurso inexplorado para descubrir nuevos procesos biológicos. Además, se identificaron 11 genes que podrían tener la capacidad de matar o inhibir bacterias, hongos e incluso virus.
Con el aumento de la resistencia a los antibióticos en todo el mundo, los conocimientos que se obtienen de estos microbios antiguos se vuelven cada vez más valiosos. Estudiar los genomas preservados en hielo ayuda a los científicos a rastrear cómo la resistencia emergió y se propagó mucho antes de que existiera la medicina moderna. La doctora Purcarea concluyó que "estas bacterias antiguas son esenciales para la ciencia y la medicina, pero se deben implementar medidas de manejo y seguridad cuidadosas en el laboratorio para mitigar el riesgo de propagación descontrolada".
Lectura rápida
¿Qué descubrieron los científicos en Rumania?
Hallaron una bacteria de 5,000 años en una cueva de hielo que es resistente a varios antibióticos modernos.
¿Quién lideró la investigación?
La investigación fue liderada por la doctora Cristina Purcarea del Instituto de Biología de Bucarest.
¿Cuáles son las implicancias del hallazgo?
La bacteria podría ayudar a entender el desarrollo de la resistencia a los antibióticos y también tiene potencial biotecnológico.
¿Cómo fue recuperada la bacteria?
Se perforó un núcleo de hielo de 25 metros en la cueva para obtener la muestra sin contaminar.
¿Qué riesgos plantea el descubrimiento?
El derretimiento del hielo podría liberar estos microorganismos, propagando genes de resistencia a bacterias modernas.